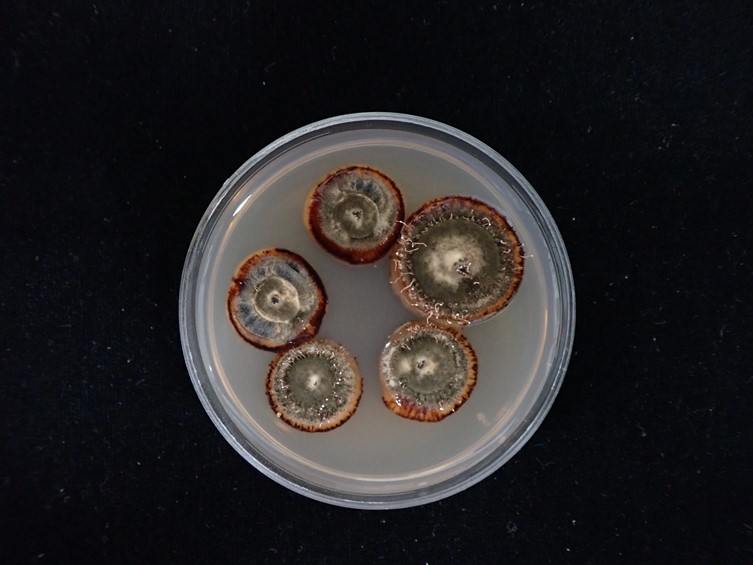

Holotype:
THAILAND, Chiang Mai Province, Ban Hua Thung community forest, 30 Oct. 2014, K. Tasanathai, A. Khonsanit, W. Noisripoom, D. Thanakitpipattana, P. Srikitikulchai, S. Wongkanoun, holotype BBH 40210, ex-type living culture BCC 76495.
Habitat:
Leaf litter.
Host:
On ant (Dolichoderus laotius).
Description:

Synnema, multiple, arising from the head, thorax, and abdomen and legs of ants, ca. 10 mm long, 100–200 μm wide. Stipes black or blackish brown, becoming pale yellow toward the 
fertile head, cells outside of stipe smooth-walled, composed of parallel hyphae being dark brown and pale toward the fertile heads, 2–5 μm wide. Fertile head at the apical region of synnemata, composed of tightly packed phialides making the hymenial layer, 15–20 μm, cylindrical to clavate, 1–2 mm long, 300–450 μm wide, pale yellow. Conidiophores biverticillate, occasionally irregularly branched with phialides growing directly from conidiophores. 
Conidiogenous cells phialidic, forming a hymenial layer. Phialides solitary or in whorls of two to four on each branch, cylindrical with papillate end, 8–22 × 1–2 μm, periclinal thickenings and collarettes absent. 
Conidia, narrowly obclavate, single, 5–8 × 1–2 μm.
Culture characteristics:
Colonies on PDA attaining a diam of 8–15 mm in 30 d, circular, raised, with dense mycelium, dark greyish reddish brown, dark brown at margin of colony. Synnema determinate, growing in the middle and on the margin of colony, cylindrical, black to brown becoming pale brown at apical region, 4–8 mm long, 80–150 μm wide. Sporulation at the apex of synnemata, with white conidial bloom. 
Conidiogenous cells phialidic, forming a hymenial layer. Phialides solitary or in whorls of two to four on each branch, cylindrical with papillate end, 5–20 × 1–2.5 μm, periclinal thickenings and collarettes absent. 
Conidia in dry chains, narrowly obclavate, 2–8 × 1–2.5 μm.
Reference:
Mongkolsamrit S, Noisripoom W, Hasin S, et al. (2023). Multi-gene phylogeny and morphology of Ophiocordyceps laotii sp. nov. and a new record of O. buquetii (Ophiocordycipitaceae, Hypocreales) on ants from Thailand. Mycological Progress 22: 5.
DOI: https://doi.org/10.1007/s11557-022-01855-4Species |
Strain |
Compound |
Pubchem CID |
Biological activity |
Reference |
|---|
|
Strain |
ON763783 | ON763784 | ON763785 | ON763786 | ON763787 |
|---|---|---|---|---|---|
| BCC 54984 | - | - | - | - | - |
| BCC 76492 | - | - | ON764218 | - | - |
| BCC 76494 | - | - | - | - | - |
| BCC 76495 | - | - | - | ON764219 | - |
| BCC 76497 | - | - | - | - | ON764220 |